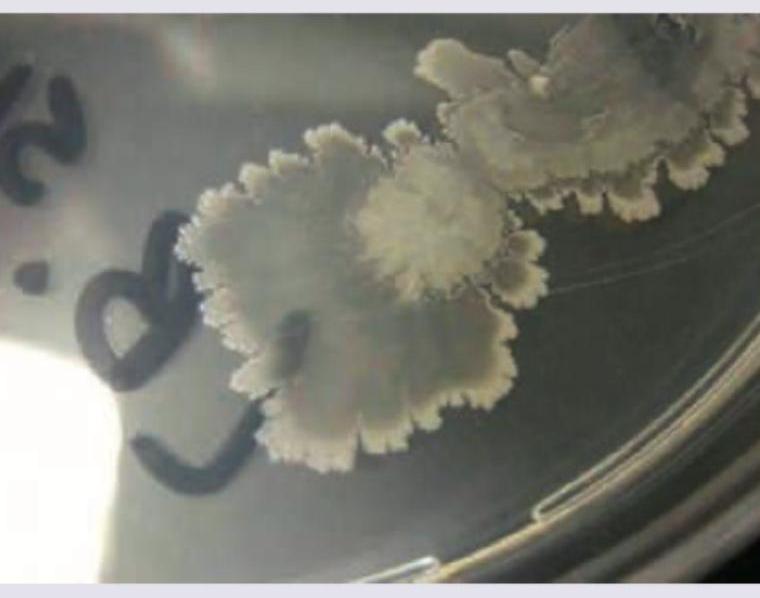
Image for question 2041

Identify the bacteria based on the colony morphology shown in the image.
Which organism is incriminated in causing the following lesions? (Recent NEET Pattern 2016-17)

A 35-year-old male farmer presents with multiple discharging cervical sinuses. Which of these stains will be useful for the diagnosis and where does this organism normally colonize in the body? (AIIMS Nov 2015)
A 24-year-old female presented with an ulcer in the genital area. A giemsa stained cervical smear was prepared. Identify the causative agent: (AIIMS Nov 2015)

A 23-year-old female presents with fever and altered sensorium for two days with rashes on legs as shown. Her BP is 70/50 mm Hg and neck stiffness is present. Lumbar puncture reveals cloudy CSF with 4200 cells/ $\mu \mathrm{L}$, protein level 198 and glucose $21 \mathrm{mg} /$ dL. Which of the following correctly describes the organism causing this condition?

The following organism shown leads to development of:

The following colony is seen with:

A 35-year-old patient presents to the OPD 24 hours after a fight with a stranger in which he was bitten. GCS is 15/15 and following injury is noted on left forearm. He complains of extreme pain and tenderness in the injury. Swab from the injury was plated in chocolate agar and incubated in 10% carbon dioxide for 48 hours. Small colonies with pitting appearance were noted. Which of the following organism is responsible?

All are true about the organism whose colonies are shown below except:

A blood smear from a patient with fever shows the following spirochetes on microscopy. Identify the organism:

Explanation: ***Bacillus anthracis*** - The image displays characteristic **“Medusa head” colonies** with irregular, wavy margins and a dull, ground-glass appearance, which are classic for *Bacillus anthracis*. - These colonies are often non-hemolytic on blood agar and are notably **non-motile**, a key differentiator from *Bacillus cereus* or *Bacillus subtilis*. *Bacillus subtilis* - While also a *Bacillus* species, *Bacillus subtilis* typically forms **spreading colonies** with a more uniform, often granular or wrinkled texture, distinct from the Medusa head morphology. - It is generally **motile** and can produce various pigments, unlike the non-motile, grayish-white colonies of *B. anthracis*. *Mycoplasma hominis* - *Mycoplasma hominis* forms very tiny colonies, often described as having a **"fried egg" appearance** due to central growth sinking into the agar and a peripheral translucent ring. - These colonies are typically **much smaller** than those seen in the image and require specialized media for growth, making them easily distinguishable. *Mycoplasma pneumoniae* - *Mycoplasma pneumoniae* also produces miniature colonies, typically taking on a **"fried egg" morphology**, but even more fastidious in their growth requirements and size than *M. hominis*. - It would not produce the large, irregular, and distinctly textured colonies observed in the provided image.
Explanation: ***Streptococcus pyogenes*** - The image depicts **impetigo**, characterized by crusted lesions, often found on the face. - **Streptococcus pyogenes** (Group A Streptococcus) is a common cause of impetigo, either alone or in combination with *Staphylococcus aureus*. *Streptococcus pneumoniae* - *Streptococcus pneumoniae* is primarily associated with **respiratory tract infections**, such as pneumonia and otitis media, not skin lesions like impetigo. - While it can cause invasive diseases, its primary presentation is typically not superficial skin infections. *Enterococcus* - *Enterococcus* species are common inhabitants of the normal **gastrointestinal flora** and are frequently implicated in **urinary tract infections**, endocarditis, and hospital-acquired infections. - They are generally not a primary cause of impetigo or similar superficial skin infections. *Staphylococcus aureus* - While *Staphylococcus aureus* is a very common cause of **impetigo**, the question asks for "the organism" as if there is only one most specific answer without providing other context, suggesting **Streptococcus pyogenes** as a highly relevant primary pathogen, especially if non-bullous impetigo is implied by the crusted appearance. - *S. aureus* often presents with **purulent lesions** (e.g., boils, carbuncles) and bullous impetigo with fluid-filled blisters which eventually rupture and crust.
Explanation: ***Modified Kinyoun acid-fast stain, mouth*** - This clinical presentation of **multiple discharging cervical sinuses** in a farmer is highly suggestive of **actinomycosis**, caused by *Actinomyces israelii*. - *Actinomyces israelii* is a **Gram-positive, non-spore-forming, anaerobic to microaerophilic rod** that is **partially acid-fast (modified Kinyoun acid-fast stain)** and a normal inhabitant of the **oral cavity, gastrointestinal tract, and female genital tract**. *Gram stain, hypopharynx* - While *Actinomyces israelii* would stain Gram-positive, the **Gram stain** alone is not specific enough to confirm actinomycosis, especially given the characteristic partially acid-fast nature. - The **hypopharynx** is not the primary or most common normal colonization site for *Actinomyces israelii*; the mouth is more accurate. *PAS, intestine* - The **Periodic Acid-Schiff (PAS) stain** is typically used to identify fungi, carbohydrates, and glycogen, not primarily *Actinomyces*. - While *Actinomyces* can be found in the intestine, it's not the most common colonization site associated with cervicofacial actinomycosis. *Grocott methenamine silver stain, vagina* - **Grocott Methenamine Silver (GMS) stain** is primarily used for the detection of fungi and some encapsulated bacteria, but not specifically *Actinomyces*. - Though *Actinomyces* can colonize the vagina, it's more commonly associated with pelvic actinomycosis, not the cervical presentation described.
Explanation: ***Hemophilus ducreyi*** - The image shows numerous small, pleomorphic, gram-negative coccobacilli arranged in **'school of fish'** or parallel chains, characteristic of **_Haemophilus ducreyi_** on a Giemsa-stained smear. - This morphology, especially from a genital ulcer, is highly indicative of **chancroid**, caused by _H. ducreyi_. *Gardnerella vaginalis* - _Gardnerella vaginalis_ is associated with **bacterial vaginosis** and is characterized by the presence of **"clue cells"** (vaginal epithelial cells covered with coccobacilli) on microscopy. - It does not form the "school of fish" arrangement seen in the image, nor does it typically cause ulcerative lesions. *Chlamydia* - **_Chlamydia trachomatis_** causes various infections, including genital ulcers in cases of **lymphogranuloma venereum (LGV)**, but it is an obligate intracellular bacterium. - It would appear as **intracellular inclusions** on a Giemsa stain and would not show extracellular coccobacillary forms arranged in clusters as depicted. *Calymmatobacterium granulomatosis* - Previously known as _Calymmatobacterium granulomatosis_, now designated as **_Klebsiella granulomatis_**, this bacterium causes **granuloma inguinale (donovanosis)**, characterized by large, beefy-red ulcers. - Diagnostic features on Giemsa stain include **Donovan bodies** (intracellular bacilli within macrophages), which are not a prominent feature in the provided image.
Explanation: ***Gram negative diplococci (kidney shaped), oxidase positive*** - The clinical presentation of **fever**, **altered sensorium**, **neck stiffness**, **petechial rash** (shown on legs), **hypotension**, and characteristic CSF findings (cloudy, high protein, low glucose, high cell count) is highly suggestive of **meningococcal meningitis**. - **Neisseria meningitidis**, the causative agent, is a **Gram-negative diplococcus** with a characteristic **kidney-bean shape** and is **oxidase-positive**. *Gram positive cocci catalase negative, bacitracin sensitive* - This description refers to **Streptococcus pyogenes** (Group A Streptococcus), which causes pharyngitis, skin infections, and rarely meningitis. - S. pyogenes meningitis is **uncommon** and does not typically present with the widespread **petechial rash** characteristic of meningococcemia. *Gram positive diplococci (lanceolate), catalase negative, optochin sensitive* - This describes **Streptococcus pneumoniae**, which is a common cause of **bacterial meningitis**, especially in adults and children. - While S. pneumoniae can cause similar CSF findings, it does not typically present with the prominent **petechial rash** and **meningococcemia** seen in this case. *Gram negative diplococci, ferments glucose only (not maltose)* - This describes **Neisseria gonorrhoeae**, which ferments **glucose** but **not maltose**, unlike N. meningitidis which ferments both. - N. gonorrhoeae typically causes **sexually transmitted infections** (urethritis, cervicitis) and rarely causes meningitis, making it unsuitable for this clinical scenario.
Explanation: ***Syphilis*** - The image displays **spirochetes**, which are characteristic of *Treponema pallidum*, the causative agent of **syphilis**. - **Syphilis** is a sexually transmitted infection that progresses through primary, secondary, latent, and tertiary stages. *Leptospirosis* - Caused by **Leptospira** species, which are also spirochetes but typically have hooked ends and are associated with exposure to contaminated water or animal urine. - Symptoms include fever, headaches, muscle aches, and occasionally severe conditions like Weil's disease (jaundice, renal failure, hemorrhage). *Lyme disease* - Caused by **Borrelia burgdorferi**, another spirochete transmitted by **ticks**. - Characterized by an expanding rash (**erythema migrans**), flu-like symptoms, and can lead to arthritis, neurological problems, and cardiac issues if untreated. *Relapsing fever* - Caused by various species of **Borrelia**, transmitted by **lice or ticks**. - Characterized by recurrent episodes of fever, headache, and muscle pain due to antigenic variation of the bacteria.
Explanation: ***Mycoplasma pneumoniae*** - The image displays characteristic **"fried egg" colonies**, which are typical for *Mycoplasma pneumoniae* when grown on appropriate agar. This morphology is due to the colony's center growing down into the agar while the periphery spreads on the surface. - This organism is a common cause of **atypical pneumonia** and lacks a cell wall. *Mycoplasma hominis* - While *Mycoplasma hominis* also forms "fried egg" colonies, they are typically **larger** and may develop more rapidly than *M. pneumoniae* colonies. - *M. hominis* is primarily associated with **genitourinary tract infections** and not typically found causing respiratory infections in the general population. *Mycoplasma genitalium* - *Mycoplasma genitalium* colonies are generally **much smaller** and more difficult to observe, often requiring specialized microscopy or staining techniques to visualize due to their extremely slow growth and small size. - This species is mainly implicated in **urogenital infections** like non-gonococcal urethritis. *Mycoplasma fermentans* - *Mycoplasma fermentans* also produces "fried egg" shaped colonies, but they are generally **smaller and less distinct** than those of *M. pneumoniae*. - This species has been associated with various conditions, including **arthritis** and opportunistic infections in immunocompromised individuals, but its colony morphology is not as classically defined as the "fried egg" for *M. pneumoniae* in typical clinical identification.
Explanation: ***Eikenella corrodens*** - The context of a **human bite wound** and the characteristic **pitting of agar** by bacterial colonies are classic identifiers for *Eikenella corrodens*. - This organism is a common inhabitant of the **oral flora** and is frequently implicated in infections resulting from human bites. *Flavobacterium meningosepticum* - This organism is more commonly associated with **nosocomial infections**, particularly in newborns and immunocompromised patients, and severe infections like meningitis or sepsis, not typically human bite wounds. - While it can grow on chocolate agar, its colonial morphology does **not typically involve pitting** of the agar. *Capnocytophaga gingivalis* - This organism is also part of the normal oral flora and can cause infections related to human bites, especially in immunocompromised individuals. - However, while it can grow on chocolate agar, it characteristically exhibits **gliding motility** and ferments carbohydrates, but does not typically cause the striking **pitting** seen with *Eikenella corrodens*. *Streptobacillus moniliformis* - *Streptobacillus moniliformis* is associated with **rat bite fever** (Haverhill fever if contracted through contaminated food or water) and not typically human bite wounds. - It often produces **"fried egg" colonies** with a dense center and a lacy edge, which is distinct from the pitting observed here.
Explanation: ***Warm agglutinin production*** - This is the **EXCEPTION** - Mycoplasma pneumoniae produces **COLD agglutinins**, not warm agglutinins - **Cold agglutinins** are IgM antibodies that agglutinate red blood cells at temperatures below 37°C and are a characteristic feature of **Mycoplasma pneumoniae** infection - **Warm agglutinins** are associated with autoimmune hemolytic anemia, not Mycoplasma infections - This is the FALSE statement, making it the correct answer in this EXCEPT question *Mulberry shaped colony* - **TRUE statement** - Mycoplasma colonies have a characteristic **"fried egg" or mulberry appearance** with a dense central zone and a flat peripheral zone - This distinctive colony morphology is due to the organisms growing into the agar surface while spreading on top - This is a key identifying feature of Mycoplasma species on culture media *Lack cell wall* - **TRUE statement** - Mycoplasma are unique among bacteria in that they **completely lack a cell wall** - This absence of cell wall makes them resistant to **beta-lactam antibiotics** (penicillins, cephalosporins) that target cell wall synthesis - The lack of cell wall also contributes to their **pleomorphism** (variable shape) and osmotic fragility - Their cell membrane contains **sterols**, which is unusual for prokaryotes *Divide by binary fission* - **TRUE statement** - Mycoplasma reproduce by **binary fission**, the standard method of bacterial reproduction - Despite lacking a cell wall, they still undergo typical prokaryotic cell division - They are the **smallest self-replicating organisms** capable of independent growth
Explanation: ***Borrelia*** - The image distinctly shows **large, coarse, and irregularly coiled spirochetes**, which are characteristic morphological features of *Borrelia* species. These are larger than other spirochetes and their coils are less tightly wound. - *Borrelia* species cause diseases like **Lyme disease** (*B. burgdorferi*) and **relapsing fever** (*B. recurrentis*), which are diagnosed by identifying these distinctive spirochetes in blood smears or tissue samples. *Treponema pallidum* - This bacterium is characterized by **thinner, tightly coiled, and regularly spaced spirals**, appearing more delicate than the organisms shown in the image. - **Darkfield microscopy** is typically used for direct visualization of *Treponema pallidum* due to its thinness and inability to be stained by Gram stain. *Leptospira* - *Leptospira* are typically **thin, tightly coiled spirochetes** with characteristic **hooked ends**, which are not visible in the provided image. - They are known for causing **leptospirosis**, a zoonotic disease. *Brucella* - *Brucella* are **small, Gram-negative coccobacilli** and are not spirochetes at all. - They cause **brucellosis**, which is a systemic infection with different microscopic appearances.
Staphylococci
Practice Questions
Streptococci and Enterococci
Practice Questions
Neisseria and Moraxella
Practice Questions
Corynebacterium and Listeria
Practice Questions
Bacillus and Clostridium
Practice Questions
Enterobacteriaceae
Practice Questions
Vibrio, Aeromonas, and Plesiomonas
Practice Questions
Pseudomonas and Related Bacteria
Practice Questions
Haemophilus and HACEK Group
Practice Questions
Bordetella and Brucella
Practice Questions
Mycobacteria
Practice Questions
Spirochetes
Practice Questions
Get full access to all questions, explanations, and performance tracking.
Start For Free